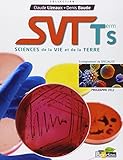
SVT term S : Sciences de la vie et de la terre (Programme 2012)

SVT term S : Sciences de la vie et de la terre (Programme 2012)

Etat : Bon état
Auteur(s) :
Date de publication : 26-04-2012
Edition : Bordas
Type : Relié
EAN 13 : 9782047329306
Comparateur de prix pour SVT term S : Sciences de la vie et de la terre (Programme 2012)
| Marchand | |
|---|---|

| Voir l'offre |

| Voir l'offre |

| Voir l'offre |
Offre(s) pour SVT term S : Sciences de la vie et de la terre (Programme 2012)
| Expedié par | État | Prix | J'achète |
|---|---|---|---|
| Bc | Comme neuf | 1,00 € | Vous devez être connecté |
| Rajaa | Bon état | 1,00 € | Vous devez être connecté |
| Libroslycee | Comme neuf | 3,00 € | Vous devez être connecté |
| Lucieducheval | Très bon état | 5,00 € | Vous devez être connecté |
| Ladyqueenkate | Comme neuf | 10,00 € | Vous devez être connecté |
Quelque chose à dire au sujet de ce livre?
+ Nos Rayons
- + Littérature
- + Jeunesse
- + Art & culture
- + Sciences humaines
- + BD, Manga & Comics
- + Histoire, actualité, politique
- + Manuels scolaires
-
+ Tourisme
- Guides touristiques Monde Afrique
- Guides touristiques Monde Angleterre-Londres
- Tourisme hors France Guides pratiques
- Guides touristiques Monde Portugal
- Guides touristiques France Provence-Alpes-Côte
- Guides touristiques France France
- Guides touristiques Monde Suisse
- Guides touristiques Monde Caraïbes
- Guides touristiques Monde Italie-Sicile-Sardaig
- Guides touristiques Monde Espagne
- + Sports & loisirs
- + Cuisine
- + Economie & entreprise
- + Nature
- + Développement durable

